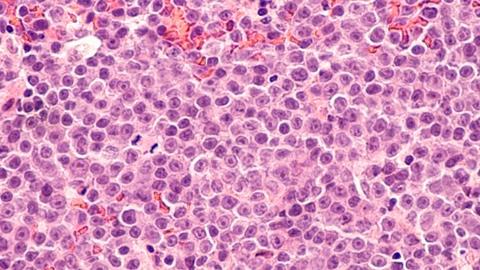
Image

European approval of the bispecific antibody treatment has the potential to change the current standard of care in diffuse large B-cell lymphoma (DLBCL).
The first CD20xCD3 T-cell-engaging bispecific antibody (BsAb) treatment to be approved in Europe for diffuse large B-cell lymphoma (DLBCL) has been granted conditional marketing authorisation.
European approval is based on results from the Phase I/II NP30179 study of Columvi® (glofitamab). Given as a fixed course, the BsAb treatment induced a complete response (CR) in 35.2 percent of the heavily pre-treated or refractory DLBCL participants. There were 50 percent who achieved an overall response. Among those who achieved a CR, 74.6 percent continued to experience a response at 12 months, while the median duration of CR was not reached.
The EC's decision for Roche's Columvi is indicated for adults with relapsed or refractory (R/R) diffuse large B-cell lymphoma (DLBCL) after two or more lines of systemic therapy.
This news follows the US Food and Drug Administration (FDA)'s approval of the anti-cancer treatment last month.
https://www.europeanpharmaceuticalreview.com/news/183650/fda-approves-off-the-shelf-bispecific-antibody-cancer-therapy/
Columvi (glofitamab) for DLBCL
As a T-cell-engaging bispecific antibody, with its “off-the-shelf availability, fixed-duration regimen and durability, Columvi will positively transform the treatment experience for relapsed or refractory diffuse large B-cell lymphoma,” stated Dr Levi Garraway, PhD, Roche’s Chief Medical Officer and Head of Global Product Development.
Given the European approval, “…patients in Europe with heavily pre-treated or refractory DLBCL will now have a new, potentially practice-changing treatment option that will allow them time off of therapy,” added Dr Michael Dickinson, PhD, principal study investigator and Associate Professor at Peter MacCallum Cancer Centre and Royal Melbourne Hospital, Australia.
What is the bispecific antibody treatment's mechanism of action?
Columvi is a CD20xCD3 T-cell-engaging BsAb designed to target CD3 on the surface of T-cells and CD20 on the surface of B-cells. The T-cell-engaging BsAb is engineered to have one region that binds to CD3 and two regions that bind to CD20, which can be healthy or malignant. This dual-targeting brings the T-cell close to the B-cell, activating the release of cancer cell-killing proteins from the T-cell.
Topics
- Advanced therapies manufacturing
- Anti-Cancer Therapeutics
- Big Pharma
- Bioprocessing and biomanufacturing
- Cancer
- Clinical Development
- Clinical Trials
- Columvi (glofitamab)
- diffuse large B-cell lymphoma (DLBCL)
- Dr Levi Garraway
- Drug Development
- European Commission (EC)
- Formulation and drug delivery
- glofitamab
- Industry Insight
- Lymphoma
- Pharmacovigilance and safety oversight
- Regulation and compliance
- Roche
- Therapeutics


